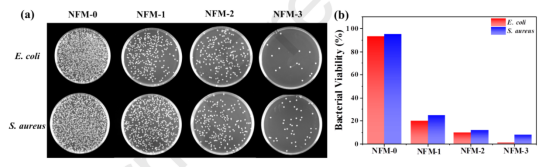

DOI: 10.1016/j.cej.2021.132111
鉴于废水中污染物对人体和环境的危害,迫切需要开发一种可同时去除染料、重金属和细菌的多功能聚合物吸附剂。在此,采用辐射接枝和静电纺丝相结合的方法制备了离子液体(IL)接枝聚醚砜(PES)(PES-g-IL)纳米纤维膜(NFMs)。检测了所制备纳米纤维材料的吸附行为、抗菌性能以及可重复使用性。研究发现PES-g-IL NFMs对重金属离子和染料表现出优异的吸附性能以及良好的可回收性。阴离子染料刚果红(CR)和重金属离子(Cd(II))的吸附容量分别达到120.3和187.3mg/g。经证实CR的吸附机理是NFMs与CR之间的静电相互作用,而Cd(II)的吸附是由接枝离子液体咪唑环上的氮原子与Cd(II)之间的络合物驱动的。吸附动力学研究表明,CR和Cd(II)的吸附符合拟二级动力学方程,这表明吸附过程受多步控制。热力学参数计算表明CR和Cd(II)的吸附是一个自发的物理吸附过程。此外,PES-g-IL NFMs具有优异的抗菌性能,对大肠杆菌的杀灭率接近99%。鉴于上述优势,PES-g-IL NFMs在废水处理方面显示出巨大的潜力。

图1.不同NFMs的形态:不同NFMs的SEM图像(a-d)和相应纳米纤维直径分布曲线。

图2.(a)水滴的代表性图像(分别在0s、20s、40s和60s时拍摄);(b)不同NFMs的时间相关接触角。数据表示为平均值±SD,n=3。

图3.(a)不同NFMs对CR的吸附能力;(b)不同NFMs对Cd(II)的吸附能力。

图4.溶液pH值对CR(a)和Cd(II)(b)在NFM-3上吸附的影响。

图5.温度对CR(a)和Cd(II)(b)在NFM-3上的吸附容量的影响。

图6.(a)NFM-0和NFM-3的Zeta电位(平均值±SD,n=3);(b)PES-g-IL NFMs的阴离子染料吸附机理示意图。

图7.IL中N1s的特征XPS峰(a),吸附Cd(II)的NFM-3中N1s和Cd3d的特征XPS峰(b),IL和IL-Cd(II)复合物的FTIR光谱(c),PES-g-IL NFMs的Cd(II)吸附机理。(a)中的插图显示了IL的咪唑鎓阳离子结构。

图8.根据Langmuir方程(a,c)和Fruendlich方程(b,d)得出CR(a,b)和Cd(II)(c,d)在NFMs上的吸附等温线。

图9.CR吸附的拟一级动力学模型、拟二级动力学模型和粒子内扩散模型(a-c);Cd(II)在NFM-3上吸附的相应动力学模型(d-f)。

图10.不同温度下CR(a)和Cd(II)(b)吸附的相应热力学参数。

图11.NFM-3在三个吸附-解吸循环中对CR(a)和Cd(II)(b)的吸附容量和解吸率。
图12.大肠杆菌和金黄色葡萄球菌菌落的照片(a);对应于不同NFMs的细菌活性(b)。